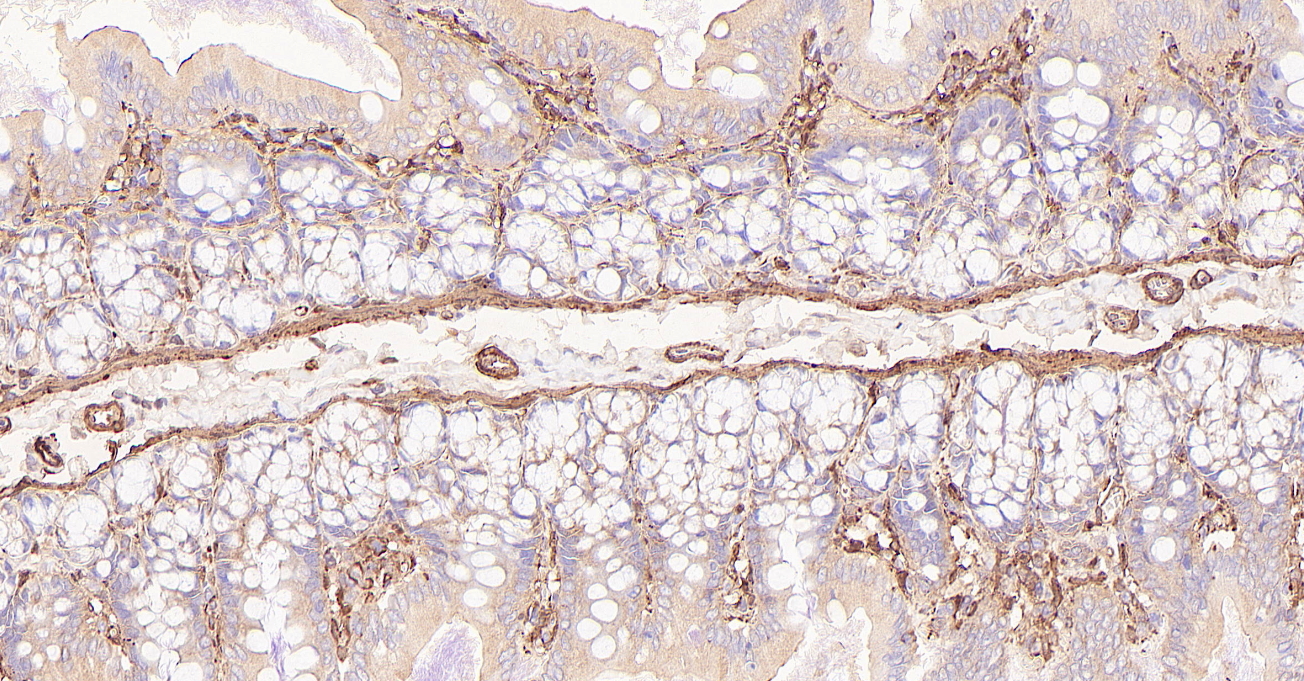

- Anti-infection
- Antibody-drug Conjugate/ADC Related
- Apoptosis
- Autophagy
- Cell Cycle/DNA Damage
- Cytoskeleton
- Epigenetics
- GPCR/G Protein
- Immunology/Inflammation
- JAK/STAT Signaling
- MAPK/ERK Pathway
- Membrane Transporter/Ion Channel
- Metabolic Enzyme/Protease
- Neuronal Signaling
- NF-κB
- PI3K/Akt/mTOR
- PROTAC
- Protein Tyrosine Kinase/RTK
- Stem Cell/Wnt
- TGF-beta/Smad
- Vitamin D Related/Nuclear Receptor
- Others
Anti-infection
Apoptosis
Cell Cycle/DNA Damage
Cytoskeleton
Epigenetics
GPCR/G Protein
- 5-HT Receptor
- Adenylate Cyclase
- Adhesion G Protein-coupled Receptors (AGPCRs)
- Adrenergic Receptor
- Amylin Receptor
- Angiotensin Receptor
- Apelin Receptor (APJ)
- Arf Family GTPase
- Arrestin
- Bombesin Receptor
- Bradykinin Receptor
- Cannabinoid Receptor
- CaSR
- CCR
- CGRP Receptor
- Chemerin Receptor
- Cholecystokinin Receptor
- CRFR
- CXCR
- EBI2/GPR183
Immunology/Inflammation
Membrane Transporter/Ion Channel
Metabolic Enzyme/Protease
- 11β-HSD
- 15-PGDH
- 17β-HSD
- 3β-HSD
- 5 alpha Reductase
- Acetolactate Synthase (ALS)
- Acetyl-CoA Carboxylase
- Acetyl-CoA synthetase
- Acyltransferase
- ADAMTS
- Adiponectin Receptor
- Aldehyde Dehydrogenase (ALDH)
- Aldehyde Oxidase (AO)
- Aldose Reductase
- Amine N-methyltransferase
- Amino Acid Oxidase
- Aminoacyl-tRNA Synthetase
- Aminopeptidase
- Aminotransferases (Transaminases)
- Amylases
Neuronal Signaling
- 5-HT Receptor
- AAK1
- Adrenergic Receptor
- Amino Acid Decarboxylase
- Amyloid-β
- Beta-secretase
- Calcineurin
- Calcium Channel
- CaMK
- Cannabinoid Receptor
- CGRP Receptor
- Cholecystokinin Receptor
- Choline Kinase
- Cholinesterase (ChE)
- COMT
- Dihydroceramide Desaturase 1 (DES1)
- Dimethylargininase (DDAH)
- FAAH
- GABA Receptor
- Glucosylceramide Synthase (GCS)
Protein Tyrosine Kinase/RTK
Stem Cell/Wnt
- Compound Screening Libraries
- Bioactive Screening Libraries
- •Bioactive Compound Library
- Drug Repurposing Series
- •FDA-Approved Drug Library
- •Drug Repurposing Compound Library
- Natural Products Series
- •Natural Product Library
- •Natural Product-like Compound Library
- Metabolism Series
- •Human Endogenous Metabolite Compound Library
- Disease Related Compound Libraries
- Signaling Pathway Series
- Fragment Libraries
- Diversity Compound Libraries
- •50K Diversity Library
- •5K Scaffold Library
- •3D Diverse Fragment Library
- Virtual Screening
- •50K Virtual Diversity Library
- •10M Virtual Diversity Library
- Recombinant Proteins
- Cytokines and Growth Factors
- Immune Checkpoint Proteins
- CAR-T Related Proteins
- CD Antigens
- Fc Receptors
- Receptor Proteins
- Enzymes & Regulators
- Complement System
- Ubiquitin Related Proteins
- Viral Proteins
- Biotinylated Proteins
- Fluorescent-labeled Recombinant Proteins
- GMP-grade Proteins
- Animal-free Recombinant Proteins
- Protein Expression Service
- Custom Synthesis Service
- ADC-Related Custom Services
- PROTAC-Related Custom Services
- Cytokines and Growth Factors
- Immune Checkpoint Proteins
- CAR-T Related Proteins
- CD Antigens
- Fc Receptors
- Receptor Proteins
- Enzymes & Regulators
- Complement System
- Ubiquitin Related Proteins
- Viral Proteins
- Biotinylated Proteins
- Fluorescent-labeled Recombinant Proteins
- GMP-grade Proteins
- Animal-free Recombinant Proteins
- Others
- View More
CAR-T Related Proteins
- CD27 Ligand/CD70
- CD4
- CD19
- CD27 Ligand/CD70
- CD123
- CD138/Syndecan-1
- Epithelial Cell Adhesion Molecule (EpCAM)
- Folate Receptor 1
- GPC-3
- Guanylate Cyclase 2C
- ErbB2/HER2
- ErbB3/HER3
- c-Met/HGFR
- MSLN
- CA-125
- ROR1
- CEACAM-5
- CD314/NKG2D
- Prostate Specific Membrane Antigen
- CD319/SLAMF7
- TROP-2
- Siglec-6
- Folate Receptor alpha (FR-alpha)
- CD314/NKG2D
- Siglec-3/CD33
- CD27 Ligand/CD70
- CD319/SLAMF7
- ErbB2/HER2
- Siglec-3/CD33
- CD7
- MUC-1/CD227
CD Antigens
- T Cell CD Proteins
- B Cell CD Proteins
- NK Cell CD Proteins
- Macrophage CD Proteins
- Monocyte CD Proteins
- Stem Cell CD Proteins
- Platelet CD Proteins
- Erythrocyte CD Proteins
- Dendritic Cell CD Proteins
- Epithelial cell CD Proteins
- Endothelial cell CD Proteins
- Signal Transduction-related CD Proteins
- Cell Adhesion-related CD Proteins
Receptor Proteins
- Receptor Tyrosine Kinases
- Receptor Serine/Threonine Kinases
- Receptor Tyrosine Phosphatase
- Receptor Guanylyl Cyclase Family
- Cell Adhesion Molecules (CAMs)
- G-Protein-Coupled Receptors (GPCRs)
- Nuclear Receptor Superfamily
- Pattern Recognition Receptors
- Notch family
- Siglec
- Leukocyte Immunoglobin-like Receptors
- Killer-Cell Immunoglobulin-like Receptors
- Cytokine Receptors
Enzymes & Regulators
- Oxidoreductases (EC 1)
- Transferases (EC 2)
- Hydrolases (EC 3)
- Lyases (EC 4)
- Isomerases (EC 5)
- Ligases (EC 6)
- Translocases (EC 7)
- Matrix Metalloproteinases
- ADAMs/ADAMTSs
- Cathepsin
- Carboxypeptidase
- Angiotensin-converting Enzymes
- Caspase
- Carbonic Anhydrase
- Serine/Threonine Kinase Proteins
- Protein Tyrosine Kinases
- Phosphatase
- Topoisomerase
- Protease Inhibitors
- Protein Kinase Inhibitor Peptide (PKI)
- Cyclin-Dependent Kinase Inhibitor Proteins
- Cystatin Family
- Molecular Biology
- •Nucleic Acid Gel Electrophoresis
- •Vector Construction
- •Restriction Endonuclease
- •Materials
- •PCR & qPCR
- •RT-PCR
- •Sequencing
- Protein Biology
- •Protein Sample Preparation
- •Protein Purification
- •Protein Electrophoresis & WB
- •Multiple Fluorescent Staining
- •Immunoassay
- •Immunoprecipitation Kit
- •Labeling Kit
- Cell Biology
- •Cell Culture
- •Cell Analysis
- •3D Cell Culture
- •Cell Isolation
- View More
Cell Analysis
- Cell Proliferation and Cytotoxicity
- Reporter Gene Testing
- Phalloidin Dye Conjugates
- Cell Apoptosis and Necrosis
- AntiFade Mounting Medium
- Mitochondrial Isolation
- Exosome Isolation, Purification and Detection
- Organelle Research
- Metabolism Assay Kit
- Mycoplasma Detection
- Biochemical Assay Kit
- Endotoxin Detection
- Quality Management System
- Custom Synthesis Service
- Bulk and Custom Synthesis Service
- ADC-Related Custom Services
- PROTAC-Related Custom Services
- Custom Reference Standard Products
- Custom Peptide Synthesis
- Protein Expression Service
- Recombinant Antibody Expression Service
- Protein Crystal Structure Elucidation
- Oligonucleotide Synthesis
- Gene Regulation Tool
- • Lentivirus Packaging
- • Adenovirus Packaging
- Fluorescent Labeling Service
- Custom Synthesis of Stable Isotope-Labeled Compounds
- One-stop CDMO Service
- One-stop Compound Screening Platform
- Virtual Screening
- Molecular Dynamics Simulation
- Cell-based Compound Screening
- Ion Channel Screening
- Kinase Screening Service
- SPR Assay Service
- GPCR Bioassay Screening Services
- Nuclear Receptor Screening Services
- Affinity Mass Spectrometry
- DEL Synthesis and Screening
- Molecular Interaction Assay Service
- Drug Target Identification Service
- AI Driven Drug Screening
- Molarity Calculator
- Dilution Calculator